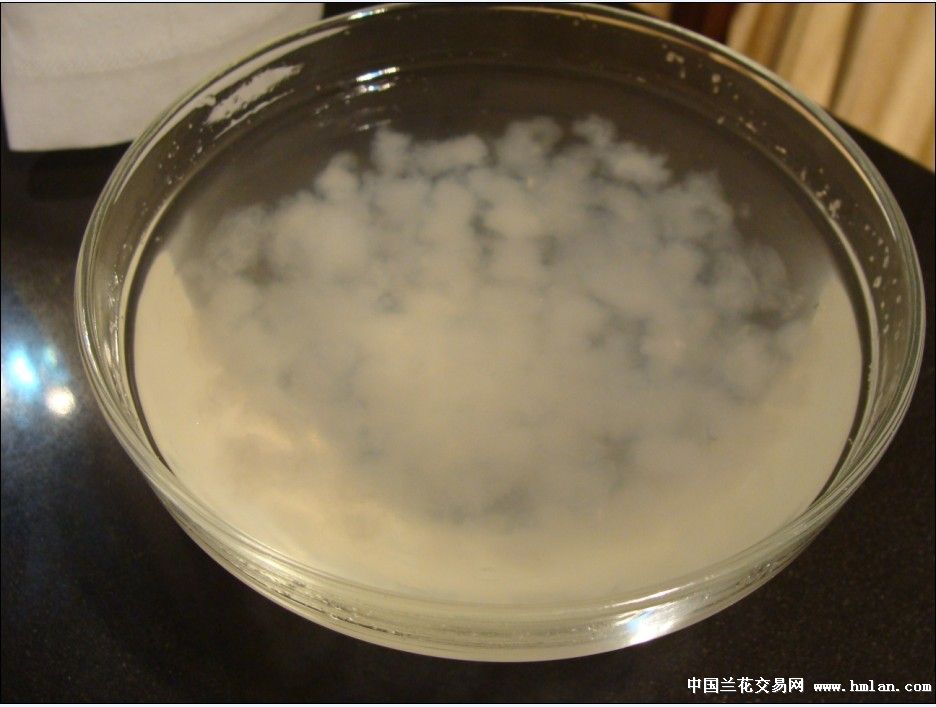
兰兄,请看林蛙油(雪蛤)泡发效果!-茶余兰后-中国
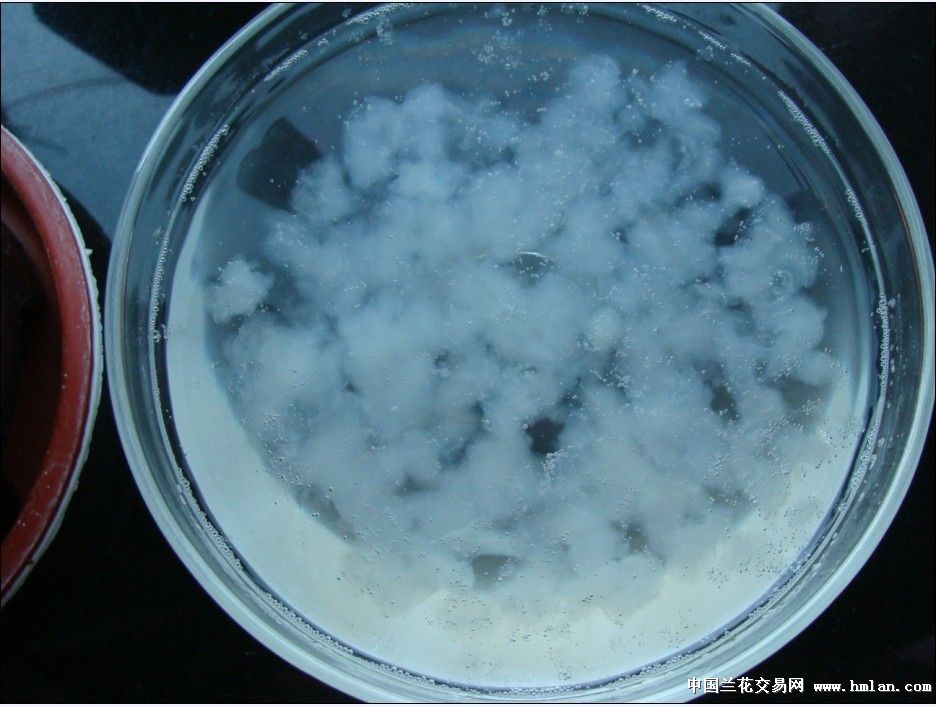
兰兄,请看林蛙油(雪蛤)泡发效果!-茶余兰后-中国

【雪蛤的泡法 】_雪蛤_做法_怎么泡_制作方法
500x273 - 50KB - JPEG

雪蛤泡出来是什么样子的
500x375 - 21KB - JPEG

雪蛤泡出来是什么样子的
500x391 - 18KB - JPEG
兰兄,请看林蛙油(雪蛤)泡发效果!-茶余兰后-中国
936x707 - 69KB - JPEG

兰兄,请看林蛙油(雪蛤)泡发效果!-茶余兰后-中国
936x707 - 84KB - JPEG

兰兄,请看林蛙油(雪蛤)泡发效果!-茶余兰后-中国
936x707 - 61KB - JPEG

东北特产 长白山特大林蛙油 雪蛤 干货泡发无杂
310x202 - 12KB - JPEG

泡发雪蛤过程附图~-19楼私房菜-杭州19楼
427x320 - 19KB - JPEG

晴天88雨天的泡好的雪蛤做法的学习成果照
600x600 - 72KB - JPEG

雪蛤泡出来是绿色的,是不是发霉了?-19楼私房
545x566 - 22KB - JPEG

轻雪旨 长白山 特级雪蛤油珍珠 特级林蛙油 泡发
618x505 - 77KB - JPEG

雪蛤泡发过程的做法_黄白小熊
200x266 - 7KB - JPEG

雪蛤泡发过程的做法_雪蛤泡发过程怎么做_雪
200x266 - 15KB - JPEG
兰兄,请看林蛙油(雪蛤)泡发效果!-茶余兰后-中国
936x707 - 93KB - JPEG

如何辨别雪蛤 教你4法挑选最佳雪蛤(2)
400x310 - 33KB - JPEG
到底要怎么泡发呢,用温水泡还是这样可以完全祛除雪蛤的腥味,而且口感更加润滑),放进碗中,加入冰糖、
用料材料 用量联体雪蛤4.8克凉白开淹没雪蛤并高出3cm姜片适量做法1.称重雪蛤4.8克随便冲洗一下,我取两个
雪蛤是有名的滋补品,深受爱美女性的喜爱,而雪蛤的做法多,那么你会几种呢?今天小编为您介绍几种常见的
雪蛤是需要浸泡的,雪蛤的正确泡法是怎样的呢?今天就跟大家说一说。首先请大家在选择雪蛤的时候尽量选择
一、雪蛤 的食用方法之一:泡发及做法 取 林蛙油 3-5克,先用清水仔细冲洗,去除杂质,然后加入适量的温水,在
树丁网之前公布过雪蛤的泡制方法。发泡雪蛤需要注意几点问题:1、雪蛤一般都是含潮的,在南方多数为干品,
雪蛤的正确泡发方法及烹饪方法雪蛤泡好后放在冰箱多久都行吗泡发后的雪蛤能放冰箱冷藏吗雪蛤泡开后冷冻三天
雪蛤油的泡发是很有讲究的。由于是联体油(雪蛤干拨出的油),所以或多或少会带有雪蛤的内脏或黑色筋膜或
小孩子正在发育的时候,如果吃了雪蛤会导致性早熟的,孕妇在怀孕期间也是不能吃雪蛤的,但是生产后就是吃